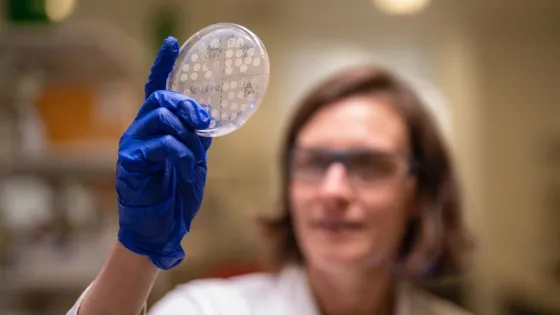

Priorities, Strengths and Opportunities
Content navigation
Research Priorities
Plants and climate change: Enhancing resilience in crops and Australian natural ecosystems.

Climate change poses one of the most pressing challenges for sustainability of agriculture and native ecosystems. Our work aims to understand the mechanisms that enable plants to respond and adapt to climate change while maintaining productivity. Our research areas range from physiology to modelling of crop and ecosystem responses:
The understanding of plant water and carbon exchange. ANU has led research focusing on the regulation of photosynthesis - and associated trade-offs in carbon and water exchange. This work is contributing to global models for climate prediction and adaptation, helping to guide policy decisions in Australia and around the world.
Models for plant traits that can enhance their robustness in extreme environments. To help ensure sustainable and adaptable agricultural production, we seek to understand and develop resilience strategies and models for plant traits that can enhance their robustness in extreme environments. These traits can then be integrated or domesticated into high-yield crop varieties through precision breeding and gene editing without the need for foreign DNA.
Drought and heat resilience. Our goal is to identify, and integrate into crops, key genes and signalling mechanisms that enable plants to thrive in hot and dry Australian soils.
Predict changes in plant health and ecosystem function. In natural ecosystems, we employ eco-physiological and physiological approaches with genomics to understand plant responses and adaptation to climate change. We combine work on Australian native plant species with field work around the world to understand what traits enable plants to survive, and thrive, in extreme environmental gradients from alpine to hot deserts. We aim to predict changes in plant health and ecosystem function, contribute to management of native plant communities, and help to build more resilient and biodiverse plant ecosystems.
Plant Biosecurity: Managing and preventing plant diseases.

Climate change, human activity and land use change drive the emergence of new pathogen outbreaks in crops and natural ecosystems. Better prediction gives farmers and other land users tools to prevent large-scale disease outbreaks. In the longer-term, breeding of disease-resistance crops will avert major crop losses.
Genomics tools. We develop genomics surveillance tools to swifty detect emerging plant pathogens in crops and native plants, tracking their evolution over time using sensitive, high-throughput DNA sequencing for both whole genome and target loci detection.
Understanding plant immunity. Our research focuses on understanding how pathogens, in particular fungal variants in cereal crops, subvert plant immune systems to cause disease. This knowledge aids in predicting crop susceptibility and designing disease-resistant crops to boost their productivity and reduce pesticide use.
Broad spectrum defence to biotic threats. Understand how natural gene silencing mechanisms trigger broad spectrum defence to biotic threats including pathogens and insects. As the mechanism is conserved, we aim to determine the utility of its manipulations for enhanced pathogen defence in crops.
Engineering novel sources of immunity. We are using experimental and computational (AI) methods to understand how immunity receptors in plants recognise fungal pathogens. This information will enable us to redesign and re-engineer immunity receptors to restore genetic resistance in susceptible crops.
Resource-efficient crops: Enhancing nutrient and water use efficiency and sustainability under dynamic conditions.

Our advanced knowledge of plant carbon fixation, water and nitrogen use-efficiency bridges translation of basic research into practical tools for breeders and farmers. These tools identify key crop traits for breeding and engineering targets that enhance the input efficiency in crops like wheat, rice, canola and chickpea. Our research supports efficient crop design – digital domestication - through hybrid breeding, gene editing and synthetic biology. This is coupled with non-invasive phenomics tools for detecting differences in plant performance in the field to accelerate traditional breeding. Our activities aim to enhance crop yield and nutrition while reducing irrigation and fertilizer use to lower costs for farmers and environmental damage. To achieve this, our research entails:
Enhancing photosynthesis. We have designed strategies and experimental tools to improve carbon fixation efficiency by enhancing CO2 capture and its conversion into sugars and seed carbohydrate with accompanying benefits in the efficiency of plant water and nitrogen use.
Reducing nitrogen fertiliser reliance. We focus on designing crops that produce their own nitrogen fertilisers through symbiosis with beneficial soil bacteria via translating the nitrogen fixation process from legume species such as chickpea into cereal crops.
Creating better ways to breed hybrid crops. We help to develop hybrid crops that grow faster, produce more food, and handle stress like heat or drought more effectively than traditional varieties, thanks to the natural benefits of hybrid vigour.
Domesticating orphan crops for modern agriculture. We use gene-editing to target domestication genes from species that are not currently widely cultivated. One example is Brassica carinata, a plant that has potential to be grown at scale as a cover crop for the production of sustainable aviation fuel.

Biotechnological engineering: Bridging fundamental scientific discovery with industrial applications.
Our research integrates plant biology, membrane transport mechanism engineering, and sustainable technology development to address global challenges in food, water, and energy security. Our research encompasses:
Plant membrane transport mechanisms. Investigating how plants selectively separate nutrients, salts, and metals at cellular levels, particularly under environmental stress. Discovering membrane transport mechanistic functions and resolving post-translational regulation characteristics.
Salinity tolerance. We aim to reduce the toxicity of saline soils in Australian agriculture through adjustment of the membrane transport properties in plant roots and shoots.
Bio-inspired separation technologies. Developing membrane filtration systems using plant-derived protein components for applications in wastewater treatment, mineral processing, and circular economy solutions. Combines plant physiology, structural biology, and engineering to create biomimetic membrane systems that achieve molecular-scale selectivity.
Crop resilience engineering. Creating environmental stress-tolerant crops through manipulating membrane-transport-mechanism function and regulation.
Sustainable resource extraction. Designing biological solutions for critical mineral recovery and environmental remediation, including partnerships with industries.
Research Strengths

The Plant Science Division at the ANU excels in combining fundamental and applied science to understand plant function from the cellular to the ecosystem level. Our aim is to enhance plant and agro-ecosystem performance in a changing climate. Our research spans molecular, cellular, whole plant and eco-physiological scales, providing a robust foundation for applied research and identifying potential bottlenecks.
Our unique strength lies in the breadth of expertise providing a wholistic appreciation of whole plant physiology and responsiveness to environmental variations in abiotic and biotic challenges. We use natural phenomena like hybrid vigour or symbiotic nitrogen fixation, to improve yields and nitrogen use of staple crops via non-GM approaches. Our longstanding expertise in field ecology emerges from applying fundamental principles of environmental physiology and evolutionary biology in situ to predict native plant performance. Emerging strengths in synthetic biology now provide us with new avenues to engineer cells and organisms for crop and food improvement.
Our research is supported by state-of-the-art facilities, including plant phenotyping tools unique to the ANU. These tools include leaf gas exchange and isotope metabolite mapping, thermal imaging, 3D plant architectural and hyper-spectral imaging, high end microscopy, and across-scale omics tools. These activities are supported by modern controlled plant growth facilities encompassing 50+ greenhouses and growth chambers maintained with the support of professional staff as well as infrastructure to support field research. To deliver impact, we support research translation with access to synthetic biology capability, crop genetic transformation and gene editing.

The Plant Sciences Division hosts a node of the Australian Plant Phenomics Network, a node of Plant Synbio Australia and co-hosts the Australian Mountain Research Facility, all NCRIS facilities. In addition, two ARC Industrial Transformation training centres – for Future Crops and Biosecurity, together with support from the Agrifood Innovation Initiative, have been developing state-of-the art tools for plant improvement and monitoring of field crops and native ecosystems in collaboration with industry partners and government agencies.
Research Opportunities
While our emphasis will remain on enhancing our fundamental understanding of plant function, there has been a shift to more applied outcomes of our research over the past years. This is driven by our growing ability to manipulate plant traits based on our cumulative understanding of molecular and physiological mechanisms and our aim to improve agriculture and sustainable management of native ecosystems in a rapidly changing environment.
Plants and climate change:

- Identify traits and genes that improve crop performance and confer adaptive advantage of native species under future temperatures and CO2 conditions
- Manipulate crop responses to extreme weather events for food and fiber security
- Enhance crop water use efficiency and performance under drought
- Designing heat- and salinity-tolerant crops
- Develop high throughput tools for crop stress identification in breeding and agronomy
- Genomically select improved native trees for future forest adaptation and to provide shelter and protection to farm paddocks
- Inform predictive modeling, conservation and management of climate resilience in native plant communities
Plant Biosecurity:

- Resurrecting defeated resistance genes – utilise the knowledge of how disease resistance proteins in plants recognise proteins produced by fungal pathogens, to re-engineer this detection in defeated resistance genes.
- Target virulence proteins from fungal pathogens to reduce crop disease – proof-of-concept stage using experimentally and computationally derived protein binders and nanobodies to reduce fungal virulence.
- Explore the use of novel mycorrhizal fungi for inducing disease tolerance
- Build smart immunity for crops using biosensors and inducible systems for precision defence
Resource-efficient crops

- Improving crop photosynthesis to enhance yield and resource use
- Reducing fertiliser use by enabling biological nitrogen-fixing in cereals.
- Partnering with First Nations communities to combine Indigenous and contemporary knowledge for climate-resilient agriculture
- Use of endemic mycorrhizal fungi (orchid mycorrhizal fungi) to enhance growth of cereals.
- Unlocking genetic mechanisms to breed hybrid varieties in crops through conventional, non-GM approaches
- Develop high throughput tools to accelerate breeding of higher-yielding, resource-efficient crops
- Create novel cover crops for improved agricultural outcomes.
Biotechnological engineering

- Manufacturing circular economy biotechnologies
- Bioengineering resources for clean energy materials security
- Developing climate-resilient bioresources for food and water security
